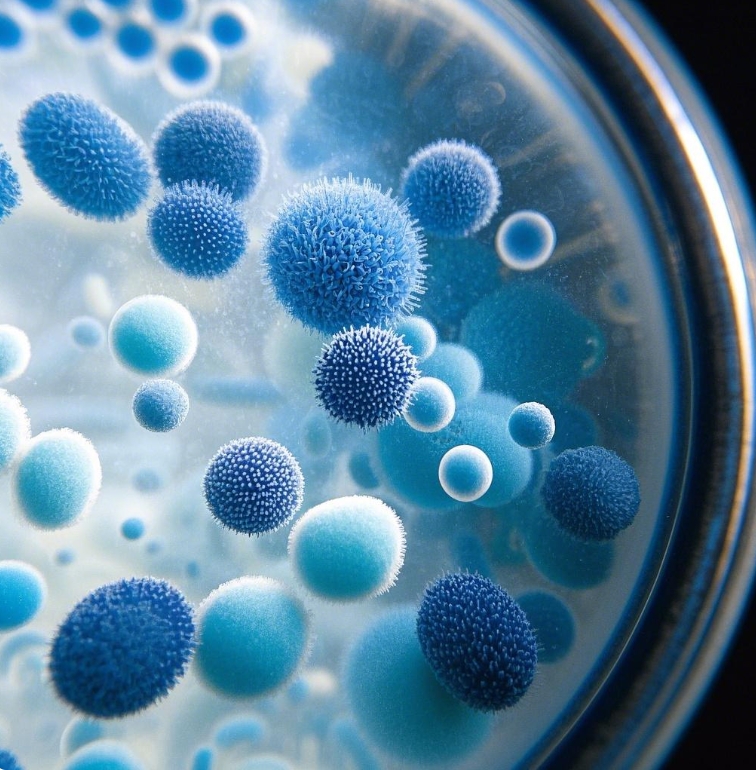

Ever wondered how scientists can copy tiny DNA pieces with great precision? The secret is Polymerase Chain Reaction (PCR). This method changed molecular biology since Kary B. Mullis invented it in the early 1980s.
PCR is a set of powerful methods for studying DNA. It lets researchers amplify and analyze genetic material with high accuracy. These advanced PCR techniques are key in genetic research, medical tests, forensic science, and more.
With the growth of PCR methods, scientists can now delve deeper into genetic studies. They can find genetic mutations and understand diseases better. These tools are vital in today’s molecular biology.
Key Takeaways
- PCR was invented by Kary B. Mullis in the early 1980s
- Multiple types of PCR methods exist for different research needs
- PCR techniques are crucial in genetic research and diagnostics
- Each PCR method offers unique advantages for specific applications
- PCR continues to evolve with technological advancements
Introduction to PCR and Its Importance
Polymerase Chain Reaction (PCR) is a key technique in molecular biology. It has changed how we do genetic research and testing. Introduced in 1985 by Kary Mullis, PCR is now vital for scientists studying DNA.
PCR’s strength is in quickly making lots of DNA copies. In just a few hours, scientists can make millions of DNA copies. This makes PCR crucial in many fields.
Overview of Polymerase Chain Reaction
PCR needs important parts to work:
- Heat-resistant Taq polymerase from Thermus aquaticus
- Free nucleotides (dNTPs)
- Template DNA
- Specific single-stranded DNA primers
Key Applications in Molecular Biology
PCR has changed many scientific areas:
- Genetic research and testing
- Forensic analysis
- Disease diagnosis
- Infectious disease monitoring
Basic Principles of PCR
The PCR process has three main steps:
- Denaturation: Separating DNA strands at 95°C
- Annealing: Primers binding at 55-72°C
- Extension: DNA replication at 75-80°C
PCR usually needs 30-40 cycles. This allows for DNA to be amplified from one molecule to millions of copies.
Conventional PCR: The Foundation
Conventional PCR is a key tool in genetic research. It helps scientists amplify specific DNA sequences. Kary Mullis developed it in the 1980s, making it a game-changer in molecular biology.
The process of conventional PCR involves several important steps. These steps greatly improve genetic research capabilities:
- DNA template preparation
- Primer design for target sequence
- Thermal cycling with specific temperature stages
- Final product visualization on agarose gel
Essential Equipment and Materials
To do conventional PCR, you need special equipment and precise materials. Researchers use the following:
- Thermocycler for temperature control
- Taq DNA polymerase (heat-resistant enzyme)
- Nucleotides (dNTPs)
- Specific primers
- DNA template
Limitations of Conventional PCR
Conventional PCR has some big limitations. It’s semi-quantitative, which means it doesn’t give exact amounts of DNA. It also has a plateau phase where it’s less reliable for precise counting.
Standard PCR uses 20-40 cycles. Each cycle has three stages: denaturation, annealing, and extension. These stages are crucial for amplifying DNA in various fields.
Real-Time PCR: Advancements in Detection
Real-time PCR is a big leap in molecular diagnostics. It gives us new ways to understand genetics. This method has changed how we measure and find DNA.
Real-time PCR, or qPCR, lets scientists watch DNA grow in real-time. It’s different from old PCR methods. This new way gives us quick and exact DNA measurements.
Mechanism of Real-Time PCR
Real-time PCR uses special fluorescent markers. These markers show how much DNA is growing. This lets researchers:
- Know how much DNA they start with
- See DNA growing in real-time
- Find genetic changes easily
Applications in Diagnostics
Quantitative PCR has changed many fields. It’s used in:
- Medical tests
- Genetic studies
- Finding diseases
- Screening for cancer
Advantages Over Conventional PCR
Real-time PCR is better than old PCR methods. It’s more accurate, faster, and safer. It gives us numbers right away, so we don’t need extra steps after.
| Feature | Real-Time PCR | Conventional PCR |
|---|---|---|
| Quantification | Immediate and precise | Requires post-PCR analysis |
| Sensitivity | High | Moderate |
| Contamination Risk | Low | High |
More and more research uses real-time PCR. From 7 studies in 1995 to 4,398 in 2005, it’s key in science and medicine.
Reverse Transcription PCR (RT-PCR): RNA Analysis
Reverse transcription PCR (RT-PCR) is a key tool in molecular biology. It lets researchers study RNA with great detail. This method changes RNA into DNA, opening up new ways to study genes and diagnose diseases.
RT-PCR is vital for understanding how genes work and finding viruses. It turns RNA into DNA for deeper analysis.
Purpose and Applications of RT-PCR
RT-PCR is used in many fields:
- Detecting viral RNA in clinical diagnostics
- Measuring gene expression levels
- Analyzing genetic disease markers
- Investigating molecular mechanisms in cancer research
The Process of Reverse Transcription
RT-PCR uses an enzyme called reverse transcriptase to change RNA to DNA. There are two main ways to do this:
- One-step RT-PCR: Does both reverse transcription and PCR in one step
- Two-step RT-PCR: Does reverse transcription and PCR separately
Differences Between RT-PCR and Regular PCR
RT-PCR is different from regular PCR because it first changes RNA to DNA. This lets researchers study RNA, which is hard to analyze directly.
RT-PCR can find very small amounts of RNA. This makes it very useful for detailed genetic studies and medical tests. Its ability to work with RNA makes it a top choice in molecular biology.
Multiplex PCR: Simultaneous Target Detection
Genetic research has seen big leaps forward thanks to new molecular methods. Multiplex PCR is a key innovation that changes how we study genes. It lets us find many DNA targets at once in one test.
Multiplex PCR is a complex way to test genes. It lets scientists work on many DNA sequences at the same time. This makes genetic tests faster and easier to do.
What is Multiplex PCR?
Multiplex PCR is a top-notch method in molecular biology. It lets scientists amplify many DNA targets in one go. By using different primers, they can study several genes at once. This saves a lot of time and money.
Benefits of Using Multiplex PCR
- Simultaneous detection of multiple genetic targets
- Reduced sample processing time
- Lower reagent consumption
- Enhanced diagnostic efficiency
- Increased sensitivity in genetic testing
Applications in Genetic Disorders
Multiplex PCR is super useful in studying and diagnosing genetic disorders. It’s shown to be great at finding different pathogens and genetic changes.
| Pathogen | Detection Rate | Patient Population |
|---|---|---|
| Enteroviruses | 77 patients | 2,162 total patients |
| HSV-1 | 20 patients | 2,162 total patients |
| VZV | 7 patients | 2,162 total patients |
Studies show multiplex PCR can spot 2 to 5 species at once. This makes it a key tool for detailed genetic studies.
Quantitative PCR (qPCR): Measuring DNA Quantity
Quantitative PCR, or qPCR, is a key tool in molecular biology. It lets scientists measure DNA and RNA with great accuracy. This method gives real-time insights into how much genetic material is present.
The strength of qPCR is its ability to track DNA amplification as it occurs. Scientists use special fluorescent signals to measure genetic material during PCR.
The Importance of Quantification
qPCR brings many benefits to genetic research:
- Precise DNA and RNA measurement
- Real-time tracking of genetic material
- High sensitivity for detecting low-quantity samples
- Applications in multiple research domains
Processes Involved in qPCR
The qPCR process includes several important steps:
- Sample preparation
- Fluorescent probe selection
- Thermal cycling
- Fluorescence measurement
- Data analysis
Comparison with Conventional PCR
qPCR is different from traditional PCR. While traditional PCR needs analysis after amplification, qPCR tracks amplification in real-time.
With qPCR, scientists can spot different genetic variations. This makes it great for finding rare genetic mutations and studying complex biological processes.
Digital PCR: Precision in Quantification
Digital PCR is a new way to measure DNA that’s very precise. It breaks down DNA into tiny parts for detailed analysis. This makes it easier for scientists to understand genetic information.
This method is special because it can count DNA exactly. It does this by splitting DNA into many small reactions. This way, scientists can find and measure genetic markers very accurately.
Overview of Digital PCR Technology
Digital PCR works differently than old PCR methods:
- It splits samples into thousands of tiny reactions.
- It uses special math to count DNA exactly.
- It can find rare genetic sequences.
- It can count DNA without needing a standard curve.
Applications and Advantages
Digital PCR is great for many scientific areas:
- Non-invasive prenatal testing finds chromosome problems 100% of the time.
- It finds tumors with very sensitive mutation detection.
- It identifies pathogens in samples.
- It analyzes rare genetic mutations.
Digital PCR can find targets as low as 0.001%, way better than old PCR.
Differences From Other PCR Methods
Digital PCR has big advantages over old PCR:
- It’s much more sensitive, finding targets at 0.1% concentration.
- It counts DNA exactly without needing standards.
- It has lower error rates, under 5%.
- It makes genetic analysis more reliable.
The tech is getting better, promising even more in genetic research and diagnosis soon.
Nested PCR: Enhancing Specificity
Genetic research needs precise DNA amplification. Nested PCR is a top-notch method for this. It boosts detection sensitivity and specificity, overcoming PCR’s limits.
The nested PCR technique is a step up from regular PCR. It uses two rounds of amplification. This makes it possible to find low-abundance genetic material with great precision.
How Nested PCR Works
Nested PCR has a special two-step process:
- First, it does a broad amplification with external primers.
- Then, it uses internal primers for a more specific target.
- This step cuts down on background noise.
- It also boosts detection sensitivity.
Key Benefits of Nested PCR
Nested PCR has many benefits:
- It can spot single DNA copies in complex samples.
- It greatly reduces false-positive results.
- It’s great for amplifying rare genetic sequences.
- It’s more specific than regular PCR.
Clinical and Research Applications
Nested PCR is key in many fields:
- Pathogen detection in clinical settings.
- Finding rare genetic mutations.
- Studying low-abundance RNA transcripts.
- Exploring complex genomic landscapes.
Nested PCR is changing genetic analysis. It offers researchers a powerful tool for detailed genetic studies.
Hot Start PCR: Reducing Non-Specific Amplification
Molecular biologists often struggle with DNA amplification, especially with complex templates or low DNA amounts. Hot-start PCR is a smart solution to cut down on non-specific amplification. It also boosts the reaction’s specificity.
Understanding Hot Start PCR
Hot-start PCR is a cutting-edge method to improve DNA amplification accuracy. It stops DNA polymerase from working at cooler temperatures. This prevents unwanted primer interactions and non-specific amplification.
- Reduces primer-dimer formation
- Increases amplification specificity
- Improves sensitivity for low-concentration DNA samples
Mechanism of Action
The main idea behind hot-start PCR is to block enzyme activity until the right temperature is hit. There are two main ways to do this:
- Antibody-mediated modification: Antibodies keep polymerase from working at room temperature
- Chemical modification: Heat-sensitive protecting groups stop enzyme interaction too soon
Research and Diagnostic Applications
Hot-start PCR is crucial in many scientific fields. It’s used for:
- Genetic disorder screening
- Forensic DNA analysis
- Pathogen detection
- Molecular diagnostics
This method greatly reduces non-specific amplification. It makes molecular biological experiments more reliable. It produces cleaner, more precise DNA fragments.
Conclusion: Choosing the Right PCR Method
The world of PCR methods is always changing. It offers many advanced types of PCR for different scientific needs. When picking a PCR method, you must think about your research goals, the type of sample, and what you want to achieve in molecular biology.
Each PCR method has its own benefits for different uses. For example, digital PCR is great for precise measurements, while nested PCR boosts specificity. Scientists have a wide range of PCR techniques to choose from. It’s important to know what each method can do best to get the best results in gene studies, DNA typing, and more.
New PCR technologies are on the horizon. They will be smaller, more automated, and work better with other molecular biology tools. We can look forward to even better PCR methods. They will be more accurate, make fewer mistakes, and be used in more areas like medicine, law, and biotech.
As PCR technology gets better, picking the right PCR method is more important than ever. Scientists need to stay open to new methods but also understand what each can do. This way, they can do their best work in their research.
FAQ
What is Polymerase Chain Reaction (PCR)?
PCR is a groundbreaking technique in molecular biology. It was developed by Kary B. Mullis. It allows scientists to make millions of copies of a specific DNA segment.
This makes it easier to study genes, diagnose diseases, and conduct scientific studies.
What are the basic components required for PCR?
PCR needs a few key things. These include Taq polymerase, primers, dNTPs, a DNA template, and a buffer solution. Together, they work in a thermal cycler to make lots of copies of specific DNA.
What are the main steps in a PCR reaction?
PCR has three main steps. First, DNA strands are separated at high temperature. Then, primers bind to specific DNA sequences.
Finally, DNA polymerase makes new strands. These steps are repeated to amplify the DNA.
What is the difference between conventional PCR and real-time PCR?
Conventional PCR gives results after the reaction is done. Real-time PCR, on the other hand, monitors DNA amplification as it happens. It’s more precise and sensitive.
When is Reverse Transcription PCR (RT-PCR) used?
RT-PCR is used for RNA analysis. It first converts RNA to cDNA before amplifying it. This is key for studying gene expression and detecting RNA viruses.
What are the advantages of multiplex PCR?
Multiplex PCR can amplify many DNA targets at once. It’s faster, more efficient, and can detect multiple genes or mutations in one go. This is great for genetic disorder testing.
How does digital PCR (dPCR) differ from traditional PCR methods?
Digital PCR breaks a sample into thousands of tiny reactions. This gives it unparalleled precision in DNA counting. Unlike traditional PCR, it doesn’t need standard curves and can find rare genetic variations accurately.
What is the purpose of nested PCR?
Nested PCR boosts DNA amplification’s specificity and sensitivity. It uses two PCR rounds with different primers. This method is excellent for finding low-copy targets and reducing non-specific amplification.
What makes hot start PCR unique?
Hot start PCR stops DNA polymerase until the reaction heats up. This cuts down on non-specific amplification and primer-dimer formation. It makes PCR more specific and reliable, especially with tough templates.
How do I choose the right PCR method for my research?
Choosing the right PCR method depends on your sample, sensitivity needs, research goals, and resources. Look at each PCR technique’s features and match them to your needs.

Leave a Comment
Your email address will not be published. Required fields are marked *